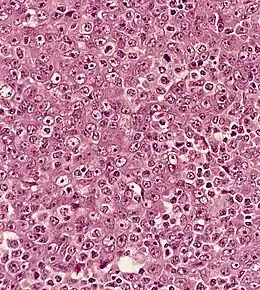
Description de cette image, également commentée ci-après

Carcinome du nasopharynx
dans un ganglion lymphatique (apparence syncytiale, noyau vésiculaire proéminent)
| Causes | Infection à virus d'Epstein Barr (en) |
|---|
| Spécialité | Oncologie |
|---|
| CIM-10 | C11 |
|---|---|
| CIM-9 | 147 |
| OMIM | 161550 |
| DiseasesDB | 8814 |
| eMedicine | ped/1553 |
| MeSH | D009303 |
![]() Mise en garde médicale
Mise en garde médicale
Le carcinome du nasopharynx est un cancer se développant à partir des cellules épithéliales du nasopharynx. Il fait partie des cancers des voies aérodigestives supérieures. Il s'agit du cancer épithélial le plus fréquent chez l'adulte.
Cette tumeur peut rester localisée ou s'étendre vers la base du crâne, l'oropharynx, la cavité buccale et le palais. Les métastases sont typiquement des métastases ganglionnaires cervicales. Ces métastases sont souvent le mode de diagnostic de ce cancer. La biopsie donnant le diagnostic. Les autres signes comprennent douleur, trismus, otite, régurgitation nasale par parésie nerveuse, perte de l'audition et paralysie de nerfs crâniens.
Plusieurs causes sont identifiées : l'infection à virus d'Epstein-Barr, des facteurs génétiques et des facteurs environnementaux comme les nitrosamines.
Le traitement repose sur la radiothérapie, la chimiothérapie et l'utilisation d'interféron.
Épidémiologie
Il s'agit du cancer épithélial le plus fréquent chez l'adulte mais il peut apparaître dès l'enfance, puisqu'au Royaume-Uni l'incidence annuelle varie de 0,3 entre 0 et 14 ans, à 2 cas pour un million d'habitants entre 15 et 19 ans. Certaines populations ont une incidence plus élevée comme en Chine et en Tunisie. Ce cancer est responsable d'un tiers des cancers du rhinopharynx. La première description de ce cancer date de 1921[1],[2].
Étiologie
La détection d'ADN viral du virus d'Epstein-Barr dans le carcinome du nasopharynx des enfants, et particulièrement dans les types 2 et 3, montre que ce virus est un des facteurs dans la carcinogenèse[3]. Mais la carcinogenèse est un processus multifactoriel.
Il semble que le taux de l'ADN détectable dans le plasma des malades soit corrélé avec la réponse au traitement[4],[5] et au risque de récidive[5].
Chez les adultes plusieurs autres facteurs sont en cause : facteurs génétiques, alimentation (particulièrement le poisson salé) contenant des nitrosamines volatiles[6].
Manifestations cliniques
Les métastases ganglionnaires sont souvent le mode de révélation de ce cancer. La biopsie donnant le diagnostic. Les autres signes comprennent douleur, trismus, otite, régurgitation nasale par parésie nerveuse, perte de l'audition et paralysie de nerfs crâniens.
Les autres métastases sont rares. Le poumon et les os sont les métastases les plus fréquentes.
Histologie
L'OMS divise ce cancer en trois sous-types : carcinome à cellules kératinisées, carcinome à cellules non kératinisées, carcinome indifférencié.
Les types 2 et 3 sont associés avec l'infection à virus d'Epstein-Barr.
Diagnostic

La biopsie fait le diagnostic. Une évaluation de l'extension est indispensable permettant une prise en charge optimale[7],[8].
Traitement
En raison de sa localisation, la chirurgie ne fait pas partie des moyens de traitement de ce cancer.
La chimiothérapie est actuellement considérée comme le meilleur traitement notamment le Mertens protocol NPC-91-GPOH (Society of Pediatric Oncology and Hematology) qui comprend un traitement par interféron après la chimiothérapie et la radiothérapie.
La radiothérapie permet un contrôle local de la maladie mais ne prévient pas le risque de métastase.
Notes et références
- ↑ Regaud C. « Lympho-épitheliome de l’hypopharynx traité par la röntgenthérapie » Bull Soc Franc Otorhinolaryngol. 1921;34:209-214.
- ↑ (de) Schmincke A. « Über lymphoepitheliale Geschwülste » Beitr Pathol Anat. 1921;68:161-170.
- ↑ (en) Wolf H, zur Hausen H, Becker V. « EB viral genomes in epithelial nasopharyngeal carcinoma cells » Nat New Biol. 1973;244:245-247.
- ↑ (en) Lo YM, Chay LYS, Lo K-W, Zhang J, Lee JC, Hjelm NM, Johnson PJ, Huang DP. « Quantitative analysis of cell-free Epstein-Barr virus DNA in plasma of patients with nasopharyngeal carcinoma » Cancer Res. 1999; 59:1188-1191.
- 1 2 (en) Lo YM, Chan LY, Chan AT, Leung SF, Lo KW, Zhang J, Lee JC, Hjelm NM, Johnson PJ, Huang DP. « Quantitative and temporal correlation between circulating cell-free Epstein-Barr virus DNA and tumor recurrence in nasopharyngeal carcinoma » Cancer Res. 1999;59:5452-5455.
- ↑ (en) Yu MC, Ho JH, Lai SH, Henderson BE. « Cantonese-style salted fish as a cause of nasopharyngeal carcinoma: report of a case-control study in Hong Kong » Cancer Res. 1986;46:956-961.
- ↑ (en) Greene FL, Page DL, Fleming ID, Fritz AG, Balch CM, Haller DG, Morrow M. AJCC Cancer Staging Manual 6th ed. New York: Springer - Verlag, 2002.
- ↑ (en) Ho JHC. « Clinical staging recommendations » In Nasopharyngeal Carcinoma: Etiology and Control. Edited by de The G, Ito Y. Lyon: International Agency for Research on Cancer, 1978.
Voir aussi
Articles connexes
Sources
- (en) Bernadette MD Brennan. « Nasopharyngeal carcinoma » Orphanet Journal of Rare Diseases 2006;1:23 doi:10.1186/1750-1172-1-23
- Portail de la médecine